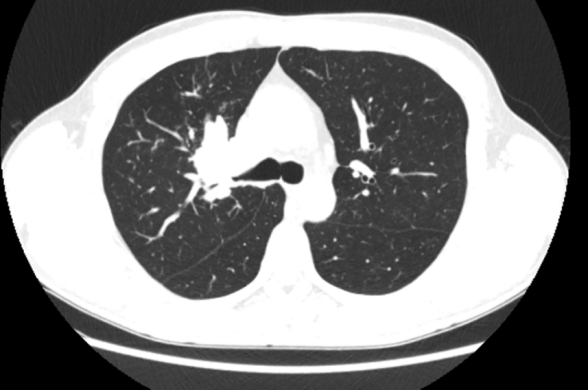
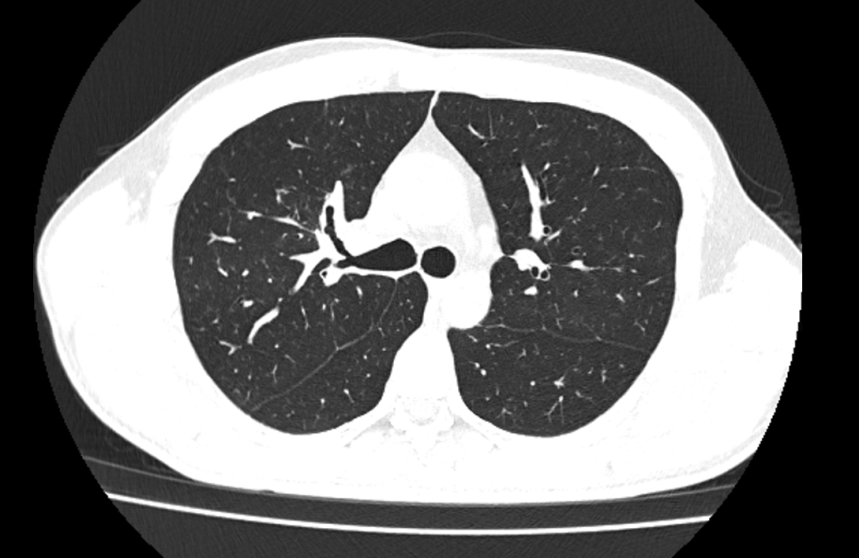

【病例1】
病人病史
患者为中青年男性,2022.08体检发现右上肺结节,在外院行结核相关检查,PPD实验(+),予以抗结核治疗一年,2024.1患者复查CT发现右上肺结节有所增大。
我院呼吸科复查增强CT:右肺上叶近端支气管壁狭窄/闭塞,内见软组织密度肿块影,较大截面大小约47X30mm。考虑为右肺上叶中央型肺癌并阻塞性肺炎,拟并右侧肺门、纵隔及右侧心膈角区淋巴结转移。
临床诊断:
初步诊断:肺癌IIIb期
活检病理(行支气管镜活检):
(右上叶新生物)组织改变为非角化型鳞状细胞癌。免疫组化结果:CK(+),TTF1(-),P40(+),SMARCA4(+),ALK-P(D5F3)(-),ALK-P(Neg)(-),Ki67(80%+),PD-L1(E1L3N)(45%+),PD-L1(Neg)(-),CD56(-),SYN(-)。
治疗过程
1、新辅助治疗过程
(1)白蛋白紫杉醇350mg+卡铂400mg+PD-1免疫抑制剂200mg方案化疗联合免疫治疗2个周期
未经过治疗前
经过2周治疗后,肺门的病灶缩小
2周期后复查见右上肺病灶缩小明显,但是2、4组的淋巴结和右侧心膈角淋巴结也没有变化。这种情况考虑治疗部分有效,原发灶CR,2、4组淋巴结无效有可能是治疗周期不够引起。
(2)继续原方案治疗2 周期,随后复查PET-CT提示原发病灶大致完全缓解,肺门转移淋巴结未见明显变化,2、4组淋巴结仍没有变化,右前心膈角区淋巴结较前相仿,但提示改区为炎性增生。MDT讨论建议手术切除右上肺叶及淋巴结清扫。
2、手术:2024年8月27日患者行胸腔镜下右上肺癌根治术
病理诊断
1). 原发灶:(右上肺叶)送检肺组织,局部见支气管粘膜增厚,粘膜增厚区及周围支气管全部取材制片:镜下见支气管软骨周围纤维组织增生伴散在及灶性淋巴细胞浸润,部分区见组织细胞聚集、胆固醇结晶沉积及多核巨细胞反应,未见坏死,未见活性癌细胞残留;结合临床病史符合肺鳞状细胞癌治疗后原发灶病理完全缓解改变。右上肺支气管残端未见癌。
2). 支气管旁淋巴结可见转移癌(1/2);(第2、4组淋巴结)送检淋巴结可见转移癌(2/3)。
3). 心包隔前的淋巴结(术前CT高度怀疑有转移):送检淋巴结未见转移癌。
3、术后将2、4组治疗后的转移淋巴结进行了类器官培养:

4、术后将2、4组治疗后的转移淋巴结进行了基因突变检测:TP53 p.R248Q EX7、SMARCA4 EX34-IVS34、PIK3CA、CCNE1、BAP1、BARD1突变。
病例特点分析及文献解读:原发灶有明显的缓解,但淋巴结没有改变,术后应该如何处理?
按照非小细胞肺癌新辅助临床试验的结果,术后没有达到PCR的患者推荐继续化疗+免疫治疗。但是该患者特点是肺癌原发灶完全缓解,转移淋巴结未见改变,术后辅助治疗按照术前新辅助方案实行化疗+免疫治疗是否合适[1-4]?
(一)根据肿瘤引流淋巴结与淋巴结微环境分类来了解肺癌淋巴结治疗效果不佳的原因如下:缺乏免疫细胞浸润和较高血管新生信号。
根据(Lao Shen, Npj Precision Oncology,2024)[1]研究表明,术后对肿瘤引流淋巴结进行分类,对肺腺癌预后有指导作用。
该研究根据肺腺癌转移形态特征,肿瘤引流淋巴结(TDLNs+)可分为单极和散在型,单极型预后明显优于散在型,中位DFS 39.9 vs 26.0个月(HR 2.03, 95%CI 1.05-3.97)。
根据TDLNs+微环境特征,分为A-D:胶原型(胶原成分>20%)、坏死型(瘤内出血、坏死)、特殊型(可见玻璃样变性、砂粒体)和普通型(缺少胶原,无坏死、玻璃样变性和砂粒体)。预后分析表明普通型最佳,特殊和坏死型较差。而这种淋巴结治疗效果差的就是缺乏免疫细胞浸润和较高血管新生信号。
因此该名患者术后的治疗中,根据这篇文献的提示,增加抗血管生成治疗可能对这类淋巴结治疗效果不佳的患者有效。
(二)类器官药敏培养:根据上述两个理论依据以及围手术期治疗指南,我们拟在不同化疗药、不同PD1抑制剂、抗血管生成抑制剂、CDK4/6抑制剂进行2、4组淋巴结的类器官药敏分析。
针对转移灶进行类器官的药敏培养。参与药敏培养的药物名单如下。
1. 白蛋白结合型紫杉醇+顺铂+PD-1免疫抑制剂+抗血管生成药物
2. 吉西他滨+顺铂+PD-1免疫抑制剂+抗血管生成药物
3. 长春瑞滨+顺铂+PD-1免疫抑制剂+抗血管生成药物
4. 多西他赛+顺铂+PD-1免疫抑制剂+抗血管生成药物
5. 第三代CDK4/6抑制剂palbociclib(帕博西尼)
6. ribociclib(瑞博西尼)
7. abemaciclib(阿贝西利)
8. 依托泊苷+顺铂+抗血管生成药物
9. 多西他赛+吉西他滨+PD-L1免疫抑制剂+抗血管生成药物
10. 吉西他滨+顺铂+PD-1免疫抑制剂+抗血管生成药物
药敏结果如下:

(三)根据病理进行分型
通过对淋巴结的病理进行基因检测,发现该病人为SMARCA4突变型肺癌,术前活检病理免疫组化发现患者是SMARCA4突变型肺癌 。该类型肺腺癌对化疗、靶向药、免疫治疗均不敏感。术后中位生存期(MST):SMARCA4(MST)缺失的病人的中位生存期42.4个月VS SMARCA4阴性患者157.7个月。CDK4/6抑制剂可能对SMARCA4突变型或缺失型肺癌有效。
讨论要点及需要解决的问题
1. 根据术前CT还是新辅助后CT选择术式?肺叶切除VS右上肺叶袖状切除?
2. 对于原发灶达到PCR,纵膈淋巴结无反应可能的原因?
3. 术后治疗方案和药物选择,是否要更改新的药物方案?类器官药敏结果是否可以指导临床?
专家点评
邵文龙:根据NCCN最新指南的观点,针对降期以后的手术评估,有三个意见:
① 按照转化后的情况进行评估;
② 按照术中探查的情况以及残端病理冰冻的情况;
③ 结合检查PET以及支气管的检查的结果,选择袖式切除还是肺叶切除。
在NCCN最新指南的框架下,残端冰冻是阴性,达到了R0切除。其中两个淋巴结发生了转移,也做了处理,是符合NCCN最新指南的要求的。
张鑫:目前我国类器官药敏指导临床诊疗尚未进入政府正式批准的阶段。2023年nature 文献中指出,类器官指导个体化治疗方案制定的敏感性可以达到70%-85%,特异性能够达到80%-90%,因此类器官药敏对于个体化诊疗方案的优化是具有可取之处的。而且由我国学者发起牵头的类器官指导肺癌新辅助治疗的2期临床试验的结果显示,类器官指导新辅助治疗方案的有效率比没有类器官药敏培养提高15%。当前临床工作中,邱主任提出的这个病例,即进行新辅助治疗后,出现原发病灶与转移病灶不同的治疗效果的病例也日益常见。因此类器官药敏培养为我们术后快速甄选对病人有效的用药手段提供了可能性。
当然,目前类器官的临床应用还存在很多瓶颈:
① 伦理的问题。在对病人的标本进行类器官药敏培养需要做好知情同意。
② 技术的瓶颈。在化疗和转化治疗阶段,类器官的培养成功率会比较低,成本较高。
③ 技术标准化的问题。验证体系不一致。
④ 免疫类器官模型:共培养T细胞、巨噬细胞等,提升免疫治疗预测准确性(如2023年《Cell》报道的“Tumor-Immune Organoid”模型),提示未来的3-5年类器官培育会带来技术的革新。
核心参考文献:
Neal JT, Li X, Zhu J, Giangarra V, Grzeskowiak CL, Ju J, Liu IH, Chiou SH, Salahudeen AA, Smith AR, Deutsch BC, Liao L, Zemek AJ, Zhao F, Karlsson K, Schultz LM, Metzner TJ, Nadauld LD, Tseng YY, Alkhairy S, Oh C, Keskula P, Mendoza-Villanueva D, De La Vega FM, Kunz PL, Liao JC, Leppert JT, Sunwoo JB, Sabatti C, Boehm JS, Hahn WC, Zheng GXY, Davis MM, Kuo CJ. Organoid Modeling of the Tumor Immune Microenvironment. Cell. 2018 Dec 13;175(7):1972-1988.e16. doi: 10.1016/j.cell.2018.11.021. PMID: 30550791; PMCID: PMC6656687.
关键贡献:首次报道了包含T细胞、巨噬细胞、树突状细胞和患者来源肿瘤细胞的类器官模型,成功模拟了免疫检查点抑制剂(如PD-1抗体)的临床反应。
⑤ 与最新的AI技术发展的融合,提出预测模型digital twin,2024年《Science Translational Medicine》提出“Digital Twin”模型(数字孪生体),虚拟筛选最优联合方案。
1、Zhang, Q., et al. (2024)."Digital Twin of Tumor-Immune Ecosystem for Virtual Screening of Combination Immunotherapies."Science Translational Medicine, 16(735), eadn3298. DOI: 10.1126/scitranslmed.adn3298
关键贡献:(1)首次将患者特异性类器官数据与多组学(单细胞RNA-seq、空间转录组)整合,构建动态数字孪生体。
(2)虚拟预测PD-1抑制剂+CTLA-4抑制剂+化疗的联合方案成功率(临床验证准确率达89%)。
(3)提出"AI-Physiology"混合建模框架(机理模型+深度学习)。
2、Laubenbacher, R., et al. (2023)."Digital Twins for Cancer Patients: A Framework for Predictive Oncology."Cell Systems, 14(5), 456-471.DOI: 10.1016/j.cels.2023.04.003
关键贡献: 理论框架:提出数字孪生的"5D"标准(Dynamic, Deterministic, Data-driven, Deployable, Divergent)。
⑥ 临床加速转化的设计。自动化的类器官培育方案能够为临床用药提供全新的用药组合。
1、Driehuis, E., et al. (2022)."Patient-Derived Organoids Guide Precision Medicine in a Prospective Clinical Trial."Cancer Discovery, 12(2), 364-383. DOI: 10.1158/2159-8290.CD-21-1084。
关键贡献: 前瞻性临床试验(NCT04279509),根据类器官药敏结果将患者分配至化疗(敏感组)或靶向治疗(耐药组)。类器官预测与临床疗效的一致性达83%。
PD-1免疫抑制类药物的类器官药敏培养
2、Woodcock, J., & LaVange, L. M. (2023)."Umbrella Trials in Oncology: Regulatory and Statistical Considerations."JAMA Oncology, 9(3), 405-412. DOI: 10.1001/jamaoncol.2022.6912
关键贡献:分层随机化(类器官结果作为分层因素)。动态适应性设计(根据中期分析调整分组比例)
3、Pasquier, A., et al. (2023)."Organoid-Driven Umbrella Trial for High-Grade Serous Ovarian Cancer (ORGANOID-HGSOC)."Nature Medicine, 29(5), 1234-1245.DOI: 10.1038/s41591-023-02317-4
关键贡献:类器官+多组学指导分组
然而,类器官药敏的评价体系不能跟现存药敏评价体系一致,类器官药敏评价更倾向于个体化治疗方案的辅助手段。
参考文献
1. Lao S, Chen Z, Wang W, Zheng Y, Xiong S, He P, Yi H, Li J, Li F, Li S, He M, Liu X, Qi C, He J, Liang W. Prognostic patterns in invasion lymph nodes of lung adenocarcinoma reveal distinct tumor microenvironments. NPJ Precis Oncol. 2024 Jul 30;8(1):164. doi: 10.1038/s41698-024-00639-1. PMID: 39080406; PMCID: PMC11289302.
2. Dacic S, Travis W, Redman M, Saqi A, Cooper WA, Borczuk A, Chung JH, Glass C, Lopez JM, Roden AC, Sholl L, Weissferdt A, Posadas J, Walker A, Zhu H, Wijeratne MT, Connolly C, Wynes M, Bota-Rabassedas N, Sanchez-Espiridion B, Lee JJ, Berezowska S, Chou TY, Kerr K, Nicholson A, Poleri C, Schalper KA, Tsao MS, Carbone DP, Ready N, Cascone T, Heymach J, Sepesi B, Shu C, Rizvi N, Sonett J, Altorki N, Provencio M, Bunn PA Jr, Kris MG, Belani CP, Kelly K, Wistuba I; IASLC Pathology Committee. International Association for the Study of Lung Cancer Study of Reproducibility in Assessment of Pathologic Response in Resected Lung Cancers After Neoadjuvant Therapy. J Thorac Oncol. 2023 Oct;18(10):1290-1302. doi: 10.1016/j.jtho.2023.07.017. Epub 2023 Sep 12. PMID: 37702631.
3. Cottrell TR, Thompson ED, Forde PM, Stein JE, Duffield AS, Anagnostou V, Rekhtman N, Anders RA, Cuda JD, Illei PB, Gabrielson E, Askin FB, Niknafs N, Smith KN, Velez MJ, Sauter JL, Isbell JM, Jones DR, Battafarano RJ, Yang SC, Danilova L, Wolchok JD, Topalian SL, Velculescu VE, Pardoll DM, Brahmer JR, Hellmann MD, Chaft JE, Cimino-Mathews A, Taube JM. Pathologic features of response to neoadjuvant anti-PD-1 in resected non-small-cell lung carcinoma: a proposal for quantitative immune-related pathologic response criteria (irPRC). Ann Oncol. 2018 Aug 1;29(8):1853-1860. doi: 10.1093/annonc/mdy218. PMID: 29982279; PMCID: PMC6096736.
4. Dacic S, Travis WD, Giltnane JM, Kos F, Abel J, Hilz S, Fujimoto J, Sholl L, Ritter J, Khalil F, Liu Y, Taylor-Weiner A, Resnick M, Yu H, Hirsch FR, Bunn PA Jr, Carbone DP, Rusch V, Kwiatkowski DJ, Johnson BE, Lee JM, Hennek SR, Wapinski I, Nicholas A, Johnson A, Schulze K, Kris MG, Wistuba II. Artificial Intelligence-Powered Assessment of Pathologic Response to Neoadjuvant Atezolizumab in Patients With NSCLC: Results From the LCMC3 Study. J Thorac Oncol. 2024 May;19(5):719-731. doi: 10.1016/j.jtho.2023.12.010. Epub 2023 Dec 7. PMID: 38070597.
【病例2】
病例背景
患者为年轻女性,主诉为反复咳嗽咳痰伴咯血2年余。2022年8月感冒后出现咳嗽、痰中带血,CT提示双肺支气管扩张伴感染(真菌感染?),肺泡灌洗mNGS检出烟曲霉菌,先后予伏立康唑、泊沙康唑治疗,4个月后因皮炎自行停药。2023年3月因咯血复发(量约100ml),复查CT示双肺支扩感染,行支气管镜检查未见新生物及出血,肺泡灌洗液mNGS检出烟曲霉菌、咽峡炎链球菌及人类疱疹病毒7型,予止血和泊沙康唑治疗后缓解。2024年3月停药后半月咯血反复,7月再次口服泊沙康唑好转。10月换用艾沙康唑,2025年2月停药再次咯血复发,本次入院进一步诊治。
既往史:2009年行房间隔缺损封堵术,余无特殊。
辅助检查
1、呼吸道病原菌核酸检测:肺炎克雷伯杆菌(+),流感嗜血杆菌(+)。
2、胸部CT检查:
(1)两肺多发支扩并感染,部分管腔内粘液栓形成,待排ABPA,请结合临床;
(2)房间隔区域金属致密影,拟术后改变;
(3)两侧肺门、纵隔多发小-稍大淋巴结,考虑反应性增生。
3、支气管检查:未见明显异常。
4、肺功能检查:小气道功能障碍。
5、肺通气灌注:
(1)双肺多发灌注功能受损灶,以左上肺前段、舌段、右下肺内基底段、前基底段为著,结合同机CT,考虑为支扩并感染;
(2)分肺灌注功能的测定:左肺占全肺的47.28%;右肺占全肺的52.72%;
(3)两侧肺门、纵隔多发淋巴结炎性增生;房间隔术后改变。
诊断:
1、双肺支气管扩张伴感染
2、房间隔缺损封堵术后
MDT讨论:
患者多次抗真菌治疗后症状可缓解,但影像学无显著改善,且停药后咯血易复发。本次入院无活动性咯血(近期停药),需进一步制定治疗方案。
讨论焦点:
1、患者有无手术指征?
2、如有手术指征,手术方式的选择?
3、如双侧肺都需要手术,手术先后顺序的选择?
专家讨论与点评
广州医科大学附属第一医院呼吸感染组叶枫教授团队的李征途主任对该病例进行了分析,观点如下:
1、诊断考虑:支气管扩张合并慢性肺曲霉菌病
· 病史>3个月,影像学提示支气管扩张伴曲霉菌感染(mNGS多次检出烟曲霉);
· 需进一步完善曲霉菌IgG检测及总IgE检测以辅助诊断(血清学抗体证据优于单纯病原学);
· 鉴别诊断:需排除变态反应性支气管肺曲霉菌病(ABPA),两者影像学部分相似,但治疗方案不同。
2、手术指征评估:当前手术指征不足
· 无大咯血(未达到100ml/次或600ml/天标准);
· 目前抗真菌疗程不足(规范疗程需一年以上);
· 患者病变范围广泛,双肺多处累及,手术风险较高。
3、优先推荐内科治疗+介入:
· 延长抗真菌疗程,维持一年以上,目的为控制病灶而非完全消除病灶;
· 在药物治疗基础上,通过介入治疗控制咯血,减少复发。
广州医科大学附属第一医院呼吸介入组洪城主任对本病例的诊疗建议进行了补充,他提到本病例比较符合慢性肺曲霉菌病的诊断,患者多发支气管扩张,影像学显示支气管腔内内容物呈新月形改变,实验室检查提示烟曲霉阳性。另外患者缺乏典型喘息症状,考虑诊断ABPA的可能性低,可进一步完善总IgE水平(ABPA通常>1000)和嗜酸粒细胞比例(ABPA通常>10%)进行鉴别。针对患者咯血的治疗,洪主任提出了以下几点建议:
1、咯血处理建议
(1)介入治疗作为首选:
· 影像学检查显示两条明显增粗迂曲的支气管动脉,可进行介入栓塞
· 咯血可能原因:支气管动脉代偿性扩张和曲霉球机械摩擦致破裂
(2)外科手术时机:
· 介入栓塞后10天左右可考虑手术
· 手术前提:目前病变广泛,定位困难,需精确定位出血靶区
(3)完善支气管镜检查:
· 术前明确出血具体部位
· 建议行NGS/TNGS检测获取病原学证据
2、抗真菌治疗建议
· 继续当前抗真菌治疗,可考虑联合支气管镜下两性霉素B局部灌注
· 提高免疫力等综合治疗
广州医科大学附属第一医院邱源主任基于中心一项关于真菌感染诊疗的回顾性研究提到,该研究发现大部分真菌感染继发于结构性肺病,包括结核空洞和先天性肺囊肿。对于咯血责任病灶定位,大多数病例出血源区与影像学最严重病变区一致,少数存在不匹配现象。邱主任认为,在活动性咯血期,可以通过急诊支气管镜检查来进一步确认出血的位置。
国家呼吸医学中心中日友好医院刘德若教授根据其医院团队对80例侵袭性真菌感染的临床病例经验总结,提出外科决策需以呼吸内科评估为基础,手术指征需要符合规范抗真菌治疗无效的局限性病变,如肺功能良好者可考虑分期肺叶切除。术后建议根据病原学检查决定是否继续抗真菌治疗,广泛病变手术需谨慎评估。对于咯血处理,支气管动脉栓塞有效率约为一半,同时需警惕非支气管动脉来源出血。
广州医科大学附属第一医院胸外科陈汉章教授对本病例进行小结,他认为该患者经过两年内科抗真菌治疗后症状改善但影像学病灶持续存在,且反复咯血,可考虑进行手术治疗切除病变。考虑到患者为年轻女性,肺功能良好,建议分期行肺叶切除,可先处理左上肺病变,3个月后再处理右下肺。手术需要注意以下事项:术前可考虑支气管动脉介入减少术中出血,术中需注意彻底松解粘连并保证余肺充分膨胀,术后请呼吸内科专家指导继续抗真菌治疗并保持充分引流。虽然病变范围较广,但在充分术前评估和精细手术操作下,手术治疗仍是合理选择,但需避免双侧同期手术,术后需长期随访监测。
本次病例讨论对双侧肺真菌感染的治疗策略更为清晰,对于真菌感染病变,亚肺叶切除是可行的治疗选择,同时需要关注个体化治疗和多学科协作的重要性